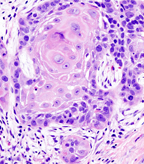

Neck dissection may no longer be the only surgical option for pathologic staging of the neck in patients with oral cavity squamous cell carcinoma, according to a new study.
Neck dissection may no longer be the only surgical option for pathologic staging of the neck in patients with oral cavity squamous cell carcinoma, according to a new study. Instead, researchers found that when properly performed, a less invasive sentinel lymph node biopsy may be adequate.
Oral cancer, well-differentiated squamous cell carcinoma in excisional biopsy specimen; source: KGH, Wikimedia Commons
In fact, in the retrospective study, the majority of patients who were positive on sentinel node biopsy had positive nodes upon neck dissection and patients who were negative on biopsy had a low rate of neck recurrence.
“Currently, patients who do not have clinically suspicious nodes undergo neck dissection for staging of the neck,” Nestor Rigual, MD, of Roswell Park Cancer Institute, told Cancer Network. “This operation is the gold standard; however, only about 30% to 40% of patients will have positive nodes, meaning roughly 60% of patients did not need the operation.”
Patients who do undergo the operation often have increased morbidity including limited mobility of the neck and chronic pain, according to the study.
Rigual and colleagues conducted this study to look at the outcomes of those patients who underwent sentinel node biopsy instead of neck dissection. The study included 38 patients with clinically T1 (47%) or T2 (53%) oral cavity squamous cell carcinoma. Any patient with positive biopsy results underwent neck dissection. The results of the study were published in JAMA Otolaryngology-Head & Neck Surgery.
After biopsy, 13% of patients (n = 5) were classified as sentinel lymph node positive. These patients went on to neck dissection and, ultimately, three were found to have additional positive lymph nodes and went on to receive chemoradiation.
The remaining 33 patients were negative upon biopsy and were followed clinically. Two of these patients developed regional recurrence.
“Sentinel lymph node biopsy in most cases of oral cancer patients with clinically negative necks was adequate for pathologic staging the lymph nodes,” Rigual said. “These results stood the test of time, meaning that very few patients who had a negative sentinel node biopsy had an isolated recurrence in the lymph nodes.”
All patients were followed for a median of 31 months to track the sensitivity of biopsy, disease-free survival, and recurrence rates.
Sentinel node biopsy had an overall sensitivity of 71% and a negative predictive value of 95% for staging the neck. Patients who were negative on biopsy had a mean disease-free survival of 65 months compared with 30 months in patients positive on biopsy (P = .08). The disease-specific survival rate for negative biopsy was 91% compared with 80% of negative biopsy.
Finally, the researchers did not identify a significant difference in disease-specific survival between the two groups.
“In spite of the limited sample size, these results are consistent with those of previous multicenter studies, which demonstrate that sentinel node biopsy is a useful procedure for pathologic staging of the cN0 neck in previously untreated patients with oral cavity cancer with the exception perhaps of floor of the mouth squamous cell carcinomas,” the researchers wrote. “These results may be useful in the development of additional multi-institutional randomized clinical trials, which are necessary to further validate sentinel node biopsy as the singular procedure for pathologic staging of the cN0 neck of patients with squamous cell carcinoma of the oral cavity.”